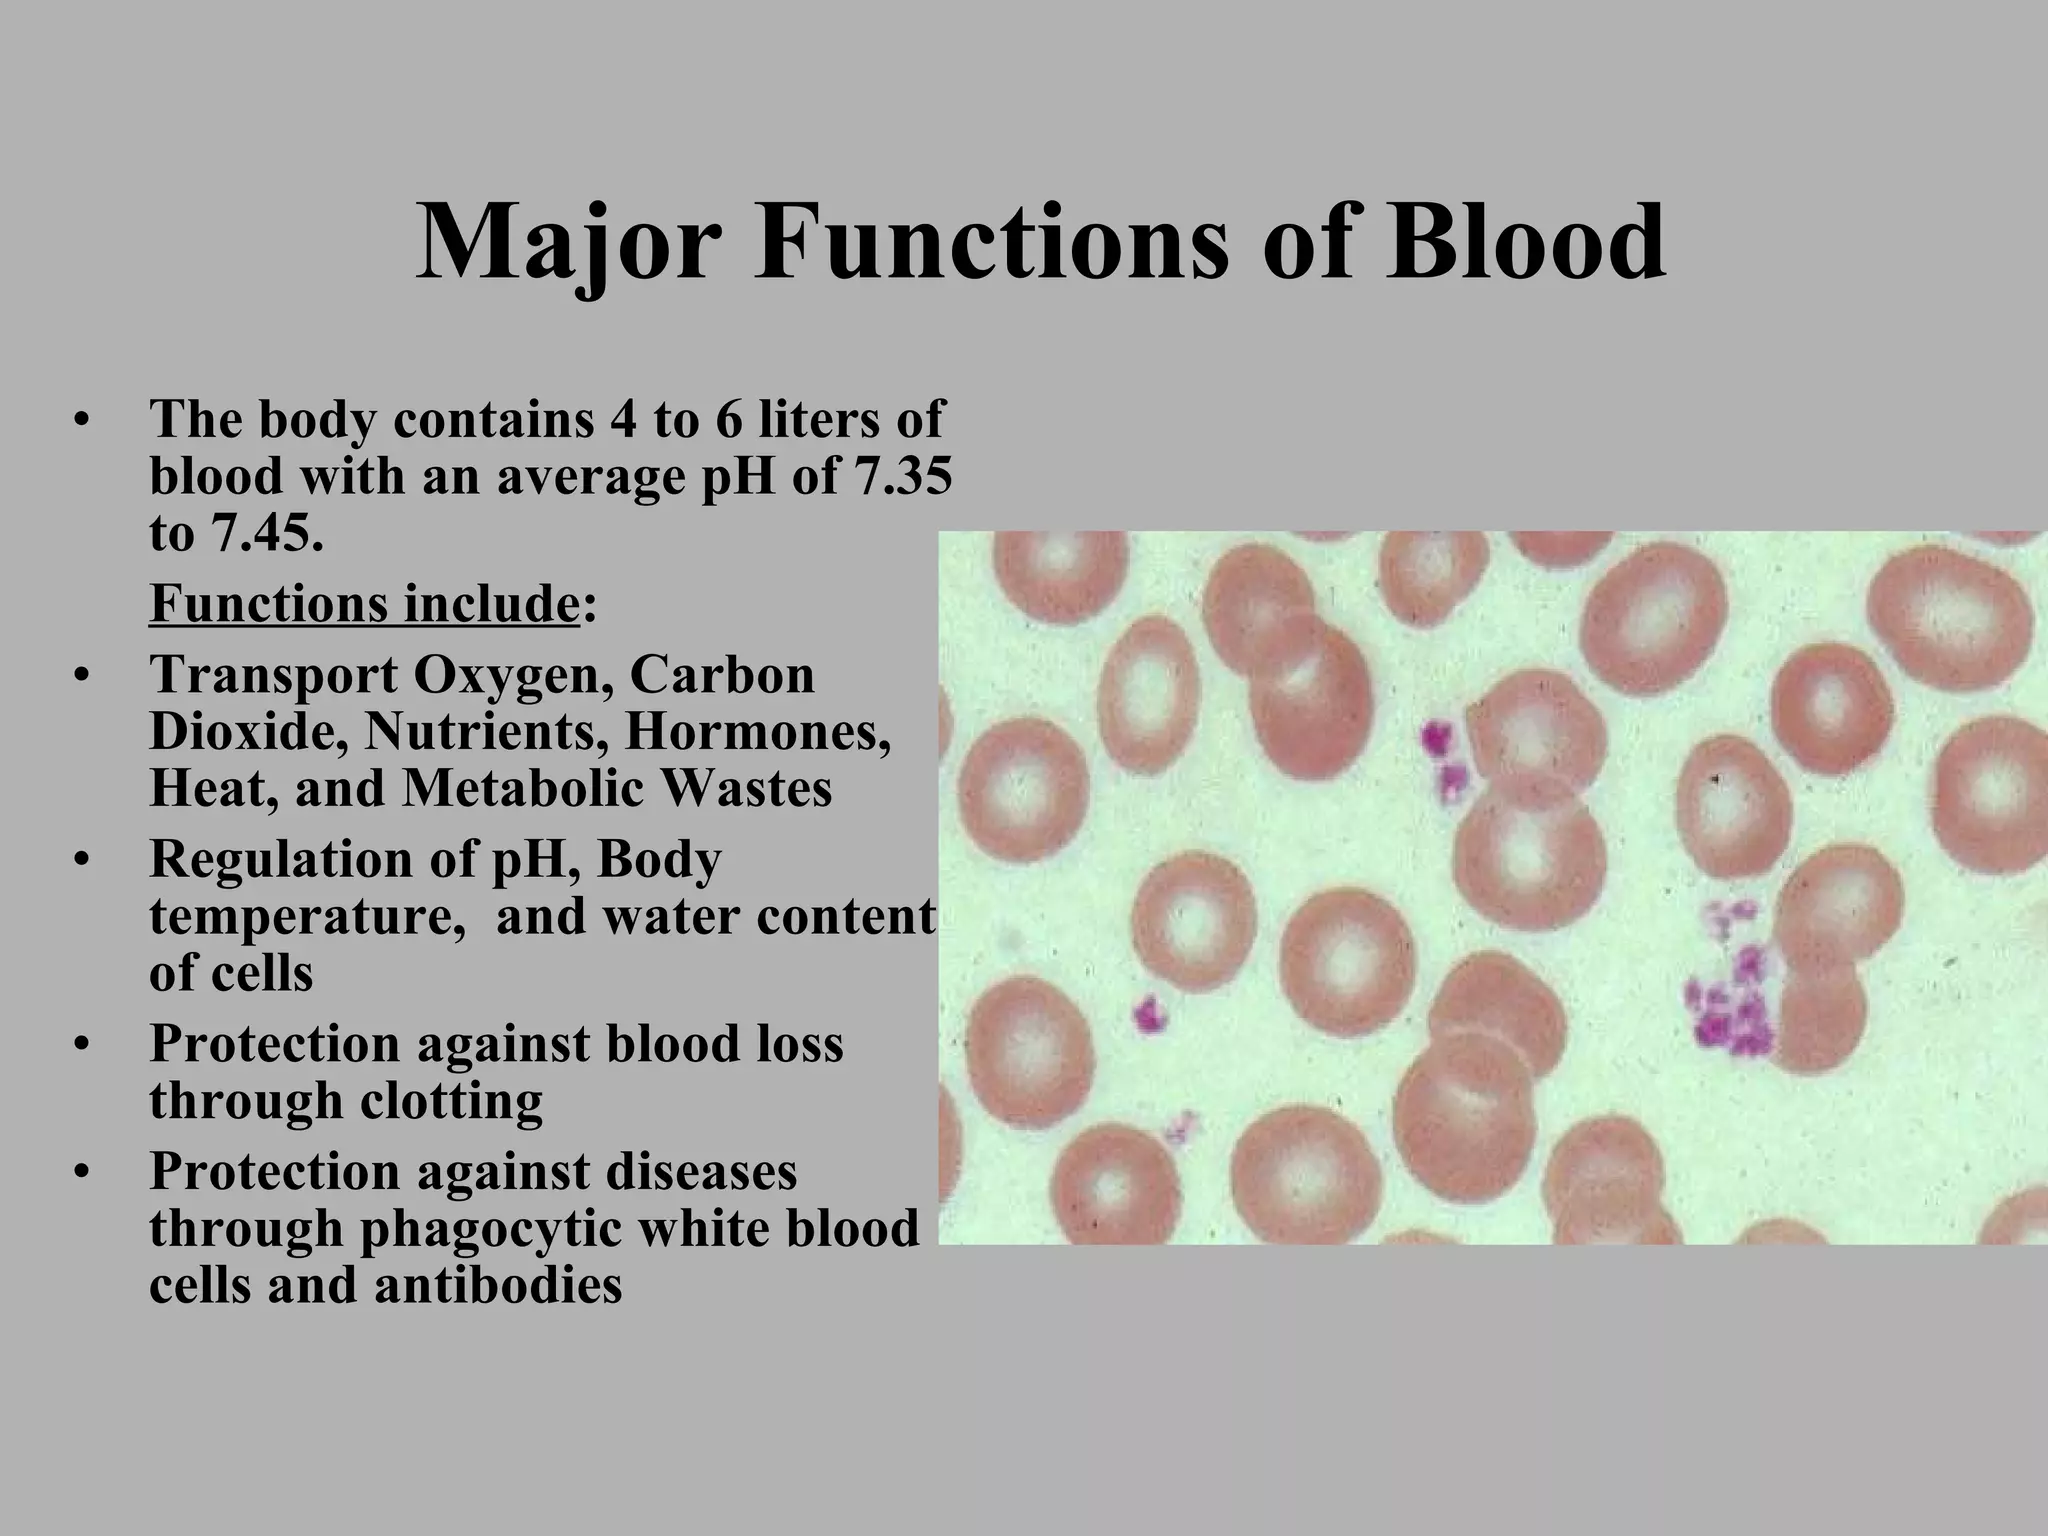
Major Functions of Blood The body contains 4 to 6 liters of blood with an average pH of 7.35 to 7.45. Functions include : Transport Oxygen, Carbon Dioxide, Nutrients, Hormones, Heat, and Metabolic Wastes Regulation of pH, Body temperature,  and water content of cells Protection against blood loss through clotting Protection against diseases through phagocytic white blood cells and antibodies

The document summarizes the major functions and components of blood. It discusses how blood transports oxygen, nutrients, hormones and removes waste products while regulating pH and temperature. Blood also protects the body through clotting and the immune response. The components of blood include red blood cells, white blood cells, platelets and plasma. Abnormalities can cause issues like anemia or clotting disorders.